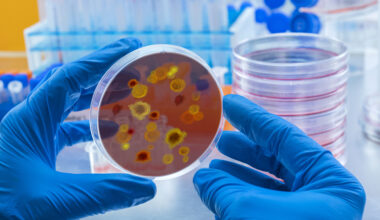

Cytek Biosciences, Inc. (NASDAQ:CTKB) is a leading global life sciences company that has redefined the field of cell analysis through its groundbreaking Full Spectrum Profiling™ (FSP®) technology. Headquartered in Fremont, California, Cytek is recognized as one of the most innovative and fast-growing players in the medical technology and biotechnology instrumentation space. The company designs, manufactures, and commercializes cutting-edge flow cytometry systems and reagents used by research institutions, pharmaceutical companies, biotechnology firms, and clinical laboratories around the world. With a mission to make high-dimensional cell analysis more accessible, affordable, and scalable, Cytek has transformed how scientists and clinicians explore the complexities of human biology, immune function, and disease progression at the cellular level.
Founded in 2015 by a team of scientists and engineers passionate about advancing cellular biology, Cytek’s vision was to overcome the limitations of traditional flow cytometry. Its flagship Full Spectrum Profiling platform revolutionized the field by capturing the complete fluorescent signature of each cell rather than measuring light through fixed bandpass filters. This technological leap enables researchers to analyze dozens of cellular markers simultaneously with higher precision, greater efficiency, and lower cost. Through this approach, Cytek has democratized access to high-parameter flow cytometry, empowering laboratories worldwide to conduct more comprehensive research in immunology, oncology, infectious diseases, regenerative medicine, and drug discovery.
The company’s product portfolio features a range of advanced instruments including the Aurora™, Northern Lights™, Aurora CS™, and Aurora Evo™ systems—each designed to deliver superior resolution and scalability for diverse research and clinical needs. Cytek’s instruments integrate seamlessly with its proprietary reagents, software, and services, creating a complete ecosystem that supports the entire cell analysis workflow. Its SpectroFlo® software, combined with a growing library of optimized reagents, allows scientists to simplify complex experimental design and analysis. This end-to-end solution model has positioned Cytek as a trusted partner for top-tier research organizations and biopharmaceutical companies seeking to accelerate innovation and improve data quality.
The Company’s DNA: Innovation Rooted in Full Spectrum Profiling Technology
Cytek’s identity is built on a deep foundation of scientific innovation. The company’s Full Spectrum Profiling (FSP®) platform has become a global benchmark for high-parameter flow cytometry, enabling scientists to capture the complete fluorescent signature of each cell instead of limited bandpass data. This leap forward allows more cellular markers to be analyzed simultaneously, increasing both accuracy and efficiency.
Cytek’s flagship systems — including Aurora™, Northern Lights™, and Aurora Evo™ — are trusted by research institutions, biotech firms, and clinical organizations worldwide. The company’s integrated model of instruments, reagents, software, and services creates a self-sustaining ecosystem, driving both technological leadership and recurring revenue growth.

CHECK THIS OUT: Corcept (CORT) Skyrockets 1,534% in 10 Years and Immuneering (IMRX) Reports 86% 9-Month Survival in Pancreatic Cancer.
Financial Resilience Backed by Record Recurring Revenues
In its latest financial report for the third quarter of 2025, Cytek Biosciences demonstrated steady progress despite a cautious macro environment. Total revenue reached $52.3 million, representing a 2% increase year-over-year. This growth was supported by a 14% increase in biotechnology, pharmaceutical, and CRO customer revenues, reflecting the expanding adoption of Cytek’s technology in clinical and commercial research.
The company’s recurring revenue — comprised of service and reagent sales — rose 19% year-over-year, a clear indicator of long-term customer loyalty and stable cash flows. This shift toward recurring income helps buffer Cytek from cyclical fluctuations in capital equipment sales and strengthens its profit margins over time.
Cytek’s installed base expanded to 3,456 instruments during Q3, with 161 new systems added in the quarter alone. The expanding user base feeds directly into higher recurring revenue, reinforcing the company’s razor-and-blade model — where instrument sales drive ongoing demand for reagents, software, and service contracts.
Expanding Global Footprint: Europe and Asia Power Future Growth
In 2025, Cytek made strategic moves to enhance its global operations. The company expanded its European headquarters in Amsterdam, increasing its footprint by over 40%. The expansion includes a dedicated customer service and training center, aimed at improving regional support, accelerating delivery, and expanding technical education programs for researchers and clinicians across the EMEA region.
Beyond Europe, Cytek continues to see strength in North America and Asia-Pacific (APAC), where double-digit revenue growth in Q3 2025 offset temporary softness in EMEA. As the company builds more distribution and support hubs worldwide, it gains the capacity to reach untapped markets and establish stronger long-term relationships with research institutions and commercial laboratories.
CEO Wenbin Jiang on Cytek’s Strategic Priorities
Commenting on the results, CEO Wenbin Jiang highlighted the company’s resilience and commitment to execution, stating:
“Our third quarter results demonstrate the strength of our established brand and technology and our market leadership position. As we look ahead, our team remains sharply focused on expanding our global installed base, growing our recurring revenue streams, and on profitability and cash generation.”
This focus on operational discipline, coupled with continued product innovation, positions Cytek for durable growth across diverse markets and economic cycles.
Financial Overview: Profit Margins, Cash Strength, and Guidance
Cytek reported a GAAP gross profit of $27.6 million for Q3 2025, with a gross margin of 53% compared to 56% a year earlier. On an adjusted basis, after accounting for stock-based compensation and amortization, the gross margin stood at 55%. While margins compressed slightly due to currency impacts and non-recurring charges, the company remains one of the most financially stable players in its segment.
Operating expenses were $36.7 million, reflecting a 10% increase year-over-year, primarily driven by litigation-related costs and a non-cash charge tied to an expired equity financing facility. Despite these one-time expenses, Cytek maintained strong financial flexibility with cash and marketable securities totaling $261.7 million as of September 30, 2025.
The company reaffirmed its 2025 full-year revenue guidance of $196 million to $205 million, representing year-over-year growth between -2% and +2%. Maintaining guidance amid macroeconomic challenges reflects management’s confidence in both the technology platform and operational execution.
Innovation Pipeline and Competitive Moat
Cytek’s growth strategy goes far beyond instrument sales. The company’s innovation pipeline includes enhancements to its existing Aurora and Northern Lights systems, as well as development of next-generation software analytics and small-particle detection technology. These innovations extend Cytek’s reach into new applications like immuno-oncology, infectious disease research, and regenerative medicine.
Unlike competitors who rely on legacy optics systems, Cytek’s spectral technology advantage allows deeper cellular profiling, making its instruments highly sought-after in both academic and commercial settings. With an installed base exceeding 3,400 units, Cytek’s network effect continues to strengthen as users rely on its reagents, training, and software to maximize instrument efficiency.
The Bullish Investment Case for Cytek Biosciences (CTKB)
The bullish thesis for Cytek Biosciences is built on three pillars: technological leadership, recurring revenue expansion, and strong financial positioning. The company’s integrated model ensures continuous customer engagement and predictable income streams. Its growing global footprint in Europe and APAC ensures geographic diversification, while its $261 million cash reserve provides a robust safety net and room for reinvestment.
Despite short-term market headwinds, Cytek’s fundamentals remain sound. With recurring revenues up 19% and the installed base growing consistently, the company’s long-term compounding potential is evident. As medtech and biotech research funding rebounds, Cytek’s systems are well-positioned to become the gold standard for high-dimensional cellular analysis.
For investors seeking exposure to next-generation life sciences infrastructure, Cytek Biosciences (NASDAQ: CTKB) represents a rare blend of defensive balance sheet strength and forward-looking innovation. Its strong execution, expanding ecosystem, and market leadership in spectral flow cytometry position the company for sustainable growth and valuation re-rating in the years ahead.
Final Thoughts: A Quiet Leader Poised for a Bright Future
Cytek Biosciences is not a hype-driven biotech story — it’s a disciplined, cash-rich, and technologically superior company executing in one of the fastest-growing niches of medical research. The expansion of its installed base, the scaling of its recurring revenue model, and the internationalization of its business all point to an accelerating growth trajectory.
With global revenue expected to exceed $200 million annually and double-digit growth across most regions, Cytek stands on the cusp of becoming the dominant name in flow cytometry innovation. Investors looking for a medtech stock with real products, global scale, and consistent execution may find Cytek Biosciences to be one of the most compelling undervalued opportunities on the NASDAQ today.
READ ALSO: Tiziana (TLSA) Surges 143% in 2025 and Immuneering (IMRX) Reports 86% 9-Month Survival in Pancreatic Cancer.